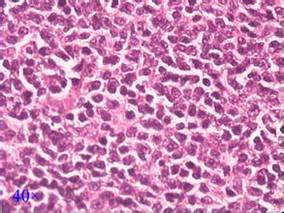
免疫化疗后放射免疫巩固对复发性滤泡性淋巴瘤患者安全有效

-
低风险MDS患者延长CC-486给药方案的有效性和安全性
环球医学资讯
2016年05月10日
点击量:664
1小时条评论低剂量DNA甲基转移酶抑制剂阿扎胞苷是目前成人骨髓增生异常综合征(MDS)或急性髓细胞白血病的标准疗法,尤其对于不能耐受高强度化疗或造血干细胞移植的老年患者而言,可有效提高患者生存质量,延长生存时间。2016年4月,发表在《Leukemia》的一项研究表明,延长口服...
-
苯达莫司汀+利妥昔单抗诱导后来那度胺维持治疗R/R C…
环球医学资讯
2016年05月09日
点击量:240
1小时条评论2016年4月,发表于《Br J Haematol》的一项研究考察了苯达莫司汀+利妥昔单抗化学免疫疗法和来那度胺维持治疗对复发、难治性慢性淋巴细胞白血病和小淋巴细胞淋巴瘤的作用。 苯达莫司汀+利妥昔单抗(BR)已被证明在复发/难治性(R/R)慢性淋巴细胞白血病(CLL)和小淋...
-
符合移植条件的套细胞淋巴瘤患者:RB/RC诱导方案安…
环球医学资讯
2016年05月09日
点击量:319
1小时条评论套细胞淋巴瘤占全部非霍奇金淋巴瘤的6%。2016年4月发表在《Br J Haematol》的一项在美国开展的研究表明,符合移植条件的套细胞淋巴瘤患者接受利妥昔单抗/高剂量阿糖胞苷(RB/RC)诱导方案安全有效。 自体干细胞移植(ASCT)后进行化学免疫疗法是新诊断为套细胞淋巴...
-
RIC HSCT治疗的淋巴瘤患者加用西罗莫司可行吗?
环球医学资讯
2016年05月09日
点击量:366
1小时条评论西罗莫司是一种大环内酯抗生素类免疫抑制剂,适用于接受肾移植的患者,预防器官排斥。2016年4月发表在《Br J Haematol》的一项多中心随机试验表明,将西罗莫司加入到降低强度预处理(RIC)异基因造血干细胞移植(HSCT)后移植物抗宿主病(GVHD)预防方案不会增加总体...
-
欧洲白血病网响应类别能可靠地预测接受TKIs治疗的CM…
环球医学资讯
2016年05月06日
点击量:199
1小时条评论2016年4月,发表于《Br J Haematol》的一项研究分析了欧洲白血病网2013年慢性粒细胞白血病慢性期中4个一线酪氨酸激酶抑制剂疗法的响应和临床结局。 本研究评估了2013年欧洲白血病网(ELN)在慢性粒细胞白血病慢性期(CML-CP)中使用常见一线酪氨酸激酶抑制剂(TKI)...
-
超早期复发滤泡性淋巴瘤患者异体移植优于自体移植
环球医学资讯
2016年05月06日
点击量:609
1小时条评论2016年4月,发表于《Br J Haematol》的一项研究考察了超早期复发和难治性滤泡性淋巴瘤前缓解期le;12月的患者中异体移植相对于自体移植的潜在获益。 尽管移植来源存在争议,早期复发或难治性滤泡性淋包瘤(FL)证明可以通过移植巩固治疗。我们分析了使用利妥昔单抗治...
-
ESA难治低风险非5q缺失MDS患者:LEN+EPO还是LEN?
环球医学资讯
2016年05月05日
点击量:484
1小时条评论2016年4月,发表在《Leukemia.》的一项研究表明,ESA难治的贫血低风险非5q缺失MDS患者中,LEN和EPO联合比LEN单用能显著改善红细胞应答。 红细胞生成刺激剂(ESAs)治疗失败后,来那度胺(LEN)使20%~30%的低风险非5q缺失骨髓增生异常综合征(MDS)患者不依赖红细胞...
-
有不利遗传突变的AML高患者也可从高剂量柔红霉素中…
环球医学资讯
2016年05月05日
点击量:227
1小时条评论柔红霉素为第一代蒽环类抗肿瘤抗生素,是周期非特异性化疗药。2016年3月发表在《Blood》的一项由美国和以色列科学家进行的研究表明,高剂量柔红霉素在急性髓细胞白血病(AML)诱导中的获益可以拓展到细胞遗传学和分子组学。 东部肿瘤协作组-美国放射学院影像网络癌...
-
标准治疗添加贝伐单抗可显著改善恶性胸膜间皮瘤总生…
环球医学资讯
2016年05月04日
点击量:904
1小时条评论恶性胸膜间皮瘤恶性程度高,预后差,自然生存期不到1年,顺铂联合培美曲塞是现在的标准疗法。2016年4月,发表在《Lancet》上的一项3期研究显示,将贝伐单抗加入到标准方案中一线治疗恶性胸膜间皮瘤可显著改善总生存期(OS)。 背景:恶性胸膜间皮瘤是一种侵袭性恶性...
-
免疫化疗后放射免疫巩固对复发性滤泡性淋巴瘤患者安…
环球医学资讯
2016年05月04日
点击量:275
1小时条评论已有研究显示,放射免疫疗法对复发性滤泡性淋巴瘤患者安全有效。2016年4月,发表在《Br J Haematol》的一项来自英国国家癌症研究所淋巴瘤研究组5年的研究结果再次证实,先前暴露于利妥昔单抗的复发性滤泡性淋巴瘤患者,短期的免疫化疗后用90Y-IT巩固治疗是有效且耐受...

会员登录

